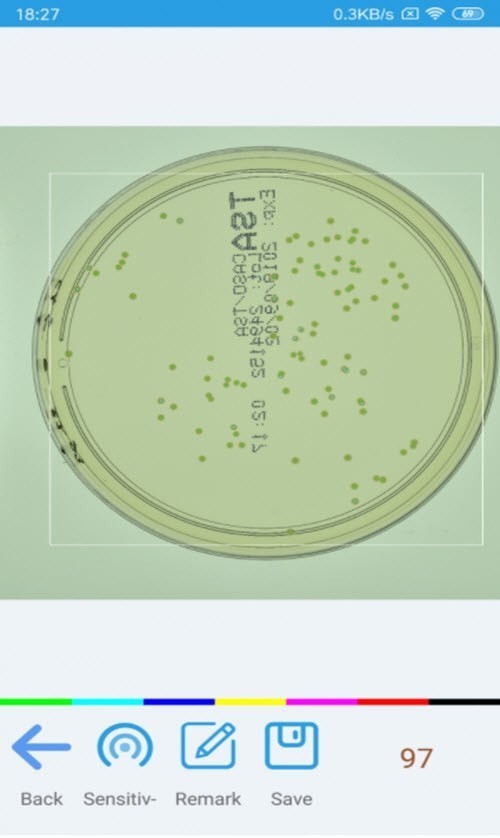
识别计数相机

识别计数相机v1.3.6免费下载



识别计数相机app是一款强大的识别技术软件,可以通过拍照一键得到照片中相同物体的数量,帮助计数各种原木,快递.弹珠类等等物品,使用简单方便,提高工作效率,十分的好用!
软件介绍
识别计数相机是一款好用的相机软件,识别功能非常的强大,你可以用它来拍照,快速的为你清点图片中的物品,使用非常方便,需要的朋友可以下载。
软件功能
有着不同的识别模式,大家可以进行不同的体验,经典的技术模式
为各位用户们提供了高精度的相机服务。软件是一款高科技的AI计算识别相机功能
提供区域圈选功能,更准确快速的进行识别,人工纠正功能,可以人工对结果进行纠正操作
软件特色
多分类统计,可以一次性统计多种分类物品,并计算每种分类物品数量
对物体尺寸无要求,可以统计多种尺寸的物品,不会因为尺寸差别而错误统计
提供不断更新的模板库,用户可通过模板库选择符合自己要求的模板进行统计
软件亮点
多分类细微差别统计,可以对两种非常相似的物品进行分类统计,如药品是否残次
对多种形态复杂物品统计准确,可统计具有多种形态物品,如人这种复杂物品也可进行精准统计
对图片杂物坑干扰性强,在复杂的图片中可以轻松识别目标物体,对其他杂物干扰有很强的过滤效果
总是帮定游戏,太让我失望啦!
简体中文的识别计数相机看起来就是方便,一目了然
视频转换软件我只认识别计数相机,功能强大不说,识别计数相机1.3.3.2软件才16.7MB。
为什么我的识别计数相机下载完以后不能安装呢?什么鬼啊
心累,总算是更新到1.10了,之前遇到的问题希望已经解决了。。
识别计数相机挺好用的一款备份软件软件,挺!!!就是下载好慢啊,赶脚那网速走的好无力
识别计数相机1.0.0.1010官方版下载好慢,不知道是不是我网速问题,继续等待……
呵呵
看到说假的我也呵呵了,不会下载的小菜鸟
神马啊 神马玩意 为啥电脑安装的时候不自带 非得下载。。。